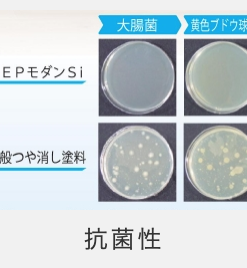

AEPモダンBIO 白
この商品は、商品数量ごとに都道府県別に定められた送料がかかります。詳しくは [ご利用方法] でご確認ください。
¥10,780 – ¥23,100 税込
内装用 汚染除去性アクリルシリコンエマルションペイント (EP-Si) <抗菌> <強力防かび・防藻> [超低VOCタイプ]
商品コード: 09a7bcd2b8aa908bc6ad4f385257da74 カテゴリー: 塗料, 機能性塗料, 抗菌・抗ウィルス塗料, 内装用塗料
内装用 汚染除去性アクリルシリコンエマルションペイント (EP-Si)
<抗菌> <強力防かび・防藻> [超低VOCタイプ]
特徴・機能
●強力防かび・防藻 抗菌剤配合 内装用汚染除去性アクリルシリコンエマルション系塗料(EP-Si)です。 ●JIS K 5663 合成樹脂エマルションペイント 1種 ※相当品(社内試験による)です。 ●「つや消し」仕上げです。 ●反応硬化形の緻密な塗膜が、汚れの付着を防ぐ低汚染タイプです。汚れた場合も、内部に浸透しませんので、中性洗剤で簡単に拭きとることができます。 ●AEPモダンSiに防かび剤・防藻剤を配合した強力防かび・防藻タイプです。 ●集合住宅・学校・病院・商業ビルなどの内部の塗替えに最適です。
概要
#8203;
| 主用途 | 建築物内壁、柱、廊下壁、階段壁 |
|---|---|
| 適用下地 | せっこうボード、モルタル、コンクリート、スレート板など |
| 主要組成 | アクリルシリコン系 |
| 荷姿 | 16kg、4kg |
| 色 | 白、指定色(淡彩まで) |
| 仕上がり(つや/模様) | つや消し(底艶) |
| 塗装器具 | 刷毛、ウールローラー、スプレー |
| 希釈剤(希釈率) | 清水(5〜10%) |
| 塗付量(塗面積) ※塗材の場合は所要量 | 0.2〜0.24kg/?/2回(66〜80?/缶) |
| 間隔時間(23℃) | 工程内2時間以上、最終養生24時間以上 |
| ホルムアルデヒド放散等級[登録] | F☆☆☆☆[日塗工] |
| JIS規格[製品特記] | JIS K 5663 合成樹脂エマルションペイント及びシーラー(合成樹脂エマルションペイント1種) [汚染除去性][抗菌][強力防かび・防藻] ※相当品(社内試験による) |
| 防火認定[製品特記] | 該当せず |
| JASS18[製品特記] | 該当せず |
| 塗装略号[製品特記] | EP-Si、EP、EP-1、AEP [汚染除去性][抗菌][強力防かび・防藻] |
| 消防法表示 (危険物登録商品名) | 非危険物[水系] |
| 適合下塗材 | カチオンホワイトBIOシーラー、サミプラホワイトBIOシーラーなど ※釘頭などの金属部は予めさび止めで拾い塗りしてください。 |
| 適合主材 | 使用しません。 |
| 適合上塗材 | 本品 |
| 備考 |
| メーカー | スズカファイン株式会社 |
|---|---|
| 容量 | 4KG, 16KG |
“AEPモダンBIO 白” の口コミを投稿します
レビューを投稿するにはログインする必要があります。
関連商品
この商品は、商品数量ごとに都道府県別に定められた送料がかかります。詳しくは [ご利用方法] でご確認ください。
新設の場合のウレタン系コンクリートモルタル用下塗材
この商品は、商品数量ごとに都道府県別に定められた送料がかかります。詳しくは [ご利用方法] でご確認ください。
適用下地は、プラスター/しっくい/繊維壁/砂壁/ケイ酸カルシウム板/水性ペンキ/パーティション/粉ふきモルタル と幅広く適用できる優れものです
-17%
対象商品のお買い上げ金額の合計に基づいて、送料が計算されます。詳しくは [ご利用方法] でご確認ください。
狭い場所や機械を持ち込むのが面倒な現場で威力を発揮するでしょう
対象商品のお買い上げ金額の合計に基づいて、送料が計算されます。詳しくは [ご利用方法] でご確認ください。
弱溶剤1液ファインウレタン、弱溶剤2液ファインウレタン、各種OPに好適のフラットベース。
この商品は、商品数量ごとに都道府県別に定められた送料がかかります。詳しくは [ご利用方法] でご確認ください。
溶剤系廃塗料固化材
この商品は、商品数量ごとに都道府県別に定められた送料がかかります。詳しくは [ご利用方法] でご確認ください。
使いやすい万能ウレタンです
この商品は、商品数量ごとに都道府県別に定められた送料がかかります。詳しくは [ご利用方法] でご確認ください。
水系廃塗料・洗浄廃液固化材

レビュー
レビューはまだありません。